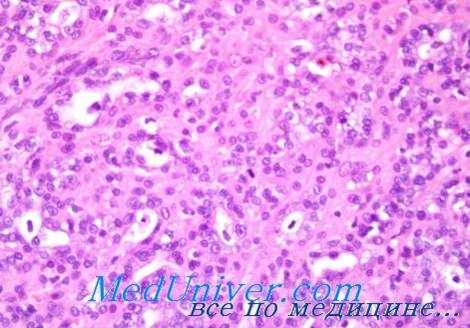
аденогенный рак век

Злокачественность аденогенного рака век. Морфология
Добавил пользователь Алексей Ф. Обновлено: 27.01.2026
Клиническая классификация рака век. Принципы
Рационально построенная клиническая классификация рака век обязательно должна отвечать трем основным требованиям клиники:
1) отражать особенности внешнего вида и анатомической формы опухоли,
2) отображать характер роста такой опухоли и
3) отмечать степень распространения поражения.
Для полноты клинической характеристики новообразования, в особенности для терапевтической цели, необходимо также учитывать состояние почвы, на которой локализуется опухоль. Но поскольку в громадном большинстве случаев рак век наблюдается на неизмененной коже, то в диагнозе отражается только патологическое ее состояние в виде соответствующего добавления к основному диагнозу. Например: «на почве волчанки», «на старом, рубце после ожога» и т. д.
В настоящее время для простоты более распространено деление рака век на два основных клинических вида: на поверхностный рак и на глубоко проникающий или инфильтрирующий рак век и его окружения.

Такое деление составляет основное условие любой простой и более детально разработанной классификации. Следует только отметить, что большинство авторов совершенно несправедливо отождествляет поверхностно растущую форму рака век с ранней стадией развития этого заболевания. Они считают, что любая мелкая поверхностная опухоль или язва по мере дальнейшего роста обязательно должна инфильтрировать подлежащую ткань, прорасти дерму и деструировать ее.
Если в большинстве случаев процесс действительно так и протекает, то известны и такие поверхностно развивающиеся формы рака век и их окружения, обозначаемые как «стелющийся» кожный рак, который при последующем росте не устремляется в толщу кожи, а все больше распространяется по ее поверхности, захватывая все большие участки кожи. Он может рубцеваться в центре, но обязательно изъязвляется по всей периферии, причем изъязвление это сугубо поверхностное.
Такие опухоли постепенно достигают громадных размеров и, как видно на рисунке, занимают значительные участки кожи лобно-височной области, где они чаще всего локализуются. Отсюда они распространяются через наружный угол глаза на веки, далее на внутренний угол глаза, на пред- и заушную области, а также на ушную раковину. Некоторые авторы стремятся отражать в своей классификации одновременно как чисто внешние признаки кожного рака, так и гистологическое строение, даже гистогенетические особенности, присущие данной опухоли.
Другие считают невозможным такое объединение и предпочитают строить свою классификацию на основе одних только внешних клинических особенностей рака кожи. В результате некоторые классификации оказываются в известной степени схематичными и страдают определенной односторонностью, поскольку они не отражают самого главного: ни роста опухоли, ни степени распространенности поражения.

Клиническая классификация рака век Г.А. Либермана
1. Грибовидно-сосочковая или экзофитная форма роста опухоли.
2. Поверхностно стелющаяся форма без изъязвления или с изъязвлением.
В зависимости от фазы развития опухоли она представляется в виде:
а) ограниченных поверхностных опухолей без изъязвления или с небольшим очень поверхностным нарушением целости эпидермиса;
б) более крупных стелющихся опухолей, образующих очень поверхностное, но весьма распространенное изъязвление, выходящее далеко за пределы века.
3. Язвенная форма роста, при которой образуется ограниченное, но глубоко проникающее изъязвление кожи века и его окружения.
4. Инфильтрирующая форма роста.
В зависимости от распространенности поражения эта форма сопровождается:
а) умеренным разрушением ткани века и относительно неглубоким прониканием инфильтрата в подлежащие ткани;
б) значительным разрушением ткани века при глубоком проникании инфильтрата в подлежащие ткани или в глазницу.
5. Смешанная форма роста, состоящая из:
а) грибовидно-изъязвленных опухолей;
б) стелющихся опухолей, но с глубоким изъязвлением,
в) инфильтрирующих опухолей с изъязвлением или других сочетаний различных форм опухолевого роста.
В приведенной классификации рак век в зависимости от роста опухоли разделен на четыре основные формы: грибовидно-сосочковую или экзофитную, поверхностно стелющуюся, язвенную и инфильтрирующую. Сюда же присоединена и смешанная форма роста, объединяющая две каких-либо из перечисленных форм. Однако в этих формах не отражается степень распространения процесса.
Последняя определяется по отношению к каждой форме отдельно и добавляется к каждому диагнозу с правой его стороны в виде обозначения соответствующей степени распространенности поражения, согласно общепринятому в нашей стране и утвержденному Министерством здравоохранения делению опухолей по клиническим стадиям поражения. Такое обозначение избавляет от необходимости введения деления па все стадии в каждой отдельной форме, чем, естественно, упрощается построение клинической классификации.
Редактор: Искандер Милевски. Дата обновления публикации: 18.3.2021
Злокачественность аденогенного рака век. Морфология
Классификация рака век
В предлагаемой классификации все эпителиальные опухоли век разбиты по гистологическому принципу на два больших основных раздела. Первый раздел включает плоскоэпителиальные или эпидермоидные опухоли кожи и конъюнктивы века, развивающиеся из многослойного плоского эпителия. Во второй раздел входят цилиндроклеточные или железистые опухоли, развивающиеся из железистого эпителия мелких желез кожи или тарзальной пластинки и края века.
Каждый из этих двух разделов в свою очередь состоит из нескольких самостоятельных групп. Раздел плоскоэпителиальных опухолей включает:
1) группу опухолеподобных, кератических и предраковых образований;
2) группу зрелых эпителиальных или доброкачественных опухолей;
3) группу незрелых или злокачественных эпителиальных опухолей кожи и конъюнктивы века.
Раздел цилиндроклеточных или железистых опухолей кожи и тарзальных пластинок века состоит из двух групп:
1) зрелые или доброкачественные цилиндроклеточные опухоли;
2) незрелые или злокачественные опухоли кожи и тарзальных пластинок века.
Помимо истинных доброкачественных и злокачественных новообразований века, в настоящую классификацию введены и некоторые заведомо неопухолевые (опухолеподобные) образования века (контактный моллюск, бугорковая ксантома, воспалительные «опухоли», кисты, развивающиеся из волосяных фолликул или из сальных желез века, а также кератические и предраковые заболевания).
Перечисленные опухолеподобные и предраковые образования наблюдаются очень часто на веках у больных, направляемых на лечение с диагнозом рака. Поэтому они являются предметом дифференциации при распознавании рака века и подлежат специальному освещению и изучению. Кроме того, большинство кератических и все предраковые образования, часто приобретающие склонность к раковому превращению, подлежат обязательной радикальной терапии, как только они правильно распознаны.

К числу кератических и предраковых образований века отнесены и разные гиперпластические процессы, главным образом дискератозы, часть которых часто служит почвой для развития карциномы. К предраковым образованиям отнесены: а) кожный рог, б) гиперкератические разрастания при пигментной ксеродерме и в) болезнь Бовена. Эти три заболевания составляют группу облигатных предраковых поражений кожи века как правило, раньше или позже претерпевающих раковое превращение.
К зрелым или доброкачественным эпителиальным опухолям кожи века отнесены папилломы.
Третью группу эпителиальных опухолей века составляют все незрелые или злокачественные опухоли этой локализации. Она состоит из 6 различных морфологических форм злокачественных новообразований кожи и конъюнктивы века. К ним относятся:
1) плоскоклеточный ороговевающий рак;
2) плоскоклеточный неороговевающий рак;
3) базальноклеточный рак;
4) более доброкачественно протекающая базалиома, отличающаяся большим разнообразием морфологической картины;
5) смешанные формы рака века;
6) разные эпителиомы века.
К разделу цилиндроклеточных или железистых опухолей века относятся опухоли аденоматозного строения века и тарзальных пластинок. Эти опухоли также разделены на зрелые, или доброкачественные, цилиндро-клеточные опухоли, составляющие первую группу опухолей этого раздела, и на незрелые, или злокачественные, входящие в состав второй группы.
К доброкачественным аденоматозным опухолям века отнесены:
1) многочисленные кисты различных желез;
2) доброкачественные аденогенные опухоли века — аденомы, исходящие из мейбомиевых желез или из других мелких желез кожи и тарзальной пластинки века.
Вторую группу — незрелые, или злокачественные, опухоли века — составляют одни только аденокарциномы, развивающиеся из мейбомиевых желез, из потовых, сальных и других желез тарзальной пластинки и кожи века.
Особенности клинического течения аденогенного рака век связаны с высокой степенью его злокачественности, которая выражается прежде всего в том, что несмотря на относительно медленное и длительное течение ракового процесса в начальном периоде развития опухоли, аденогенный рак приобретает в дальнейшем большую склонность к быстрому росту и распространению и к частому рецидивированию, особенно после не радикально проведенного хирургического лечения.
Неправильное хирургическое лечение, такое, как, например, выскабливание или вычерпывание острой ложечкой предположительного халязиона, частичное, недостаточно абластичное иссечение опухоли и т. п., не только не приводит к излечению, но, наоборот, только стимулирует приобрстание опухолью дальнейших злокачественных свойств. Высокая злокачественность адсногенного рака век заключается также в том, что он значительно чаще метастазирует, чем любой плоскоэпителиальный кожный рак века. Он метастазирует не только в регионарные околоушные и подчелюстные лимфатические узлы, как плоскоэпителиальный рак, но и в отдаленные органы и в том числе в паренхиматозные. Так, в наблюдавшемся нами случае аденогенного рака верхнего века левого глаза метастаз был обнаружен в правом легком.
Наконец, высокая злокачественность аденогенного рака век определяется тем, что он плохо поддается излечению, а несвоевременно или нерадикально излеченный аденогенный рак, как правило, всегда приводит больного к гибели, и притом в значительно более ранние сроки, чем плоскоэпителиальный рак век.
Так как количество публикуемых в литературе случаев аденогенного рака век невелико и гистогенез аденокарциномы данной локализации, как было уже указано, большей частью неоднороден, то и приводимые отдельными авторами описания морфологической структуры опухоли очень разнообразны. Каждое из них отличается теми или иными своеобразными особенностями.

Последнее обстоятельство, естественно, значительно затрудняет описание патологоанатомической картины, характерно для железистого рака век. Тем не менее мы поставили перед собой задачу попытаться путем сопоставления имеющихся в отечественной и в иностранной литературе разрозненных данных разных авторов, описывающих морфологическую картину единичных или немногочисленных случаев аденогенного рака век, и данных, полученных нами при изучении патологоанатомических препаратов 3 больных, выделить наиболее существенные признаки морфологических структур отдельных случаев рака и на основании этих данных представить патологическую картину в виде более или менее цельного и стройного описания.
Микроскопическая картина железистой гиперплазии мейбомиевой железы или истинной доброкачественной опухоли последней, как например, аденомы, представляют собой ту или иную степень гипертрофии большей или меньшей части железистой ткани, показывает нормальную анатомическую структуру железы. Здесь сохранена присущая нормальной железе узелковая доль-чатость. Дольки овальной либо более или менее округлой формы, чаще одинакового размера, равномерно увеличены, целиком инкапсулированы и окружены ясно выраженной фиброзной капсулой, исходящей из тар-зальной пластинки. Выводные протоки и железистые ходы выстланы одно- или двухслойным цилиндрическим эпителием, а в просвете железы обнаруживается присущее данной железе обычное содержимое.
Совсем иной представляется морфологическая картина аденокарциномы этой железы.
Основная гистологическая особенность, присущая аденогенному раку мейбомиевой железы в раннем периоде развития, состоит в том, что на первых порах своего роста, пока не разрушена часть тарзальной пластинки века, он заключен в последней и отграничен «хрящом» от мышечного слоя и от кожи века, сохраняет дольчатую структуру.
Морфологическая картина аденогенного рака прежде всего связана с определенными, более или менее глубокими нарушениями нормальной железистой структуры, присущей этой железе. При сохранении дольчатого строения масса опухоли состоит из иррегулярных, неравномерных по размерам и неправильных по форме и по очертаниям долек. Самой существенной особенностью последних является полное отсутствие или же прорыв капсулы вокруг них. Отдельные инкапсулированные дольки все же отделены друг от друга и разъединены более или менее четко обозначенными соединительнотканными прослойками, содержащими сосудики, питающие дольки. Эти прослойки часто оказываются инфильтрированными плазматическими клетками или лейкоцитами.
Следующая особенность морфологической картины заключается в значительном полиморфизме и в беспорядочном расположении опухолевых клеток, которые оказываются атипичными, неправильными, иррегулярными как по форме, так и по величине. При исследовании можно встретить клетки кубической, цилиндрической, полигональной, вытянутой и другой формы. Они содержат либо светлую, либо более или менее интенсивно окрашенную протоплазму и овальное, круглое или пузырчатое ядро.

Помимо такого значительного полиморфизма, клетки аденокарциномы мейбомиевой железы обладают и неравномерной восприимчивостью к красящим веществам: те клетки, которые расположены по периферии дольки, ближе к соединительной перегородке, отличаются более густо окрашенной цитоплазмой, чем клетки, расположенные более центрально.
Железистые дольки мейбомиевой железы подчас сливаются между собой в отдельных местах, образуя полости, выстланные одним рядом цилиндрических клеток, переходящих центральнее в полиэдрические клетки эпителиального типа, содержащие одно или несколько больших ядер. Иногда железистые мешочки долек значительно увеличиваются и нередко достигают гигантских размеров. Рядом могут наблюдаться кисты, выполненные жировой массой и кристаллами холестерина.
Образование такого рода кистозных полостей, возникающих по мере постепенного роста и дальнейшего увеличения размеров опухоли, приводит к изменению ее первоначальной равномерной плотности, являющейся характерной для аденогенного рака. В подобных случаях выявляются при пальпации отдельные участки размягчения опухоли соответственно локализации кистозных полостей. Наличие такого рода размягченных участков в опухоли может послужить добавочным дифференциально диагностическим признаком при клиническом распознавании железистого рака.
Строма аденогенного рака довольно разнообразна и по-разному развита. Она может состоять из плотных соединительнотканных тяжей, образующих многочисленные, различные по форме и неодинаковые по размерам петли, выполненные железистыми структурами. В других случаях она может иметь мелко- или крупноальвеолярное строение и содержать гнезда из эпителиальных клеток кругловатой или кубической формы. Преобладание стромы приводит к возникновению скиррозной формы опухоли и, наоборот, при слабо развитой строме железистые элементы явно преобладают и тогда картина аденогенного рака выступает значительно ярче.
Наконец, последняя важная морфологическая особенность рака мейбомиевой железы заключается в том, что в опухоли наравне с бластоматозными дольками, а нередко даже совсем рядом с последними, представляющими измененную до неузнаваемости ткань мейбомиевой железы, обнаруживаются участки с неизмененной, совершенно нормальной структурой железы, включенные в остатки сохранившейся тарзальной пластинки.
В случае смешения опухоли мейбомиевой железы с халязионом неправильная клиническая диагностика аденогенного рака может быть исправлена в последующем, как при появлении рецидива такого псевдохалязиона, так и при повторном, более тщательном исследовании оставшейся части биоптического материала с производством дополнительных срезов в разных плоскостях и слоях.
Если аденогенный рак мейбомиевой железы встречается исключительно редко, то этот же рак из мелких сальных желез ресниц, т. е. желез Цейсса, из рудиментарных потовых желез края века Молля и, наконец, из добавочных слезных, ацидо-тубуляриых желез Краузе, расположенных в носовой части края века, спаянного с тарзальной пластинкой, относятся к еще более редко наблюдаемым железистым формам рака век.
В литературе имеются лишь единичные описания аденогенного рака, причем они настолько лаконичны, что составить по ним более или менее полное и достаточно детальное описание клинической картины и морфологических особенностей, присущих этому раку, фактически не представляется возможным. Наиболее подробно описаны все виды аденогенного рака, как и доброкачественных опухолей, происходящих из всех четырех видов желез век, Калтом (Kalt).
В наблюдавшемся нами и приведенном здесь исключительно редком и интересном случае опухолевого поражения свободного края нижнего века левого глаза гистологическое исследование небольшой частицы ткани, взятой из этой опухоли, обнаружило в одном и том же препарате сочетание злокачественной опухоли — базалиомы — с двоякого рода доброкачественными опухолями — аденомой сальной железы ресниц и гидраденомой потовой железы края века.
Клиника аденогенного рака век. Течение
Аденогенный рак век наблюдается у лиц обоего пола, у мужчин несколько чаще, чем у женщин; как правило, в возрасте между 40 и 80 годами (Кант). Однако этот вид рака может наблюдаться и в более молодом возрасте Аллер (Allaree), Хагедорн (Hagedorn).
В отличие от плоскоэпителиального кожного рака век, наблюдаемого значительно чаще на нижнем веке, аденогенный рак поражает преимущественно верхнее веко, чем он существенно отличается от первого. Возникает аденогенный рак незаметно, исподволь, в виде небольшого отграниченного безболезненного уплотнения или утолщения с булавочную головку или с маисовое зернышко, но не на поверхности кожи, как плоскоэпителиальный рак, а подкожно или под конъюнктивой века, так как он развивается из эпителия желез, расположенных внутри тарзалыюй пластинки. Кожа при этом остается интактной.
Обнаруживается он чаще всего случайно и одинаково часто как с конъюнктивальной, так и с кожной поверхности века. Первоначальный рост его, как правило, идет очень медленно, малозаметно, не причиняя больному никаких неудобств со стороны глаза, не вызывая боли и оставаясь долго незамеченным.
В зависимости от характера первоначального возникновения и последующего развития ракового очага, моноцентрического или мультицентрического, поражение тарзальной пластинки бывает равномерным и ограниченным или узелково-бугристым. В связи в этим и первичное проявление опухоли может быть различным: либо в виде отдельного солитарного узла, либо в виде нескольких отдельных и иногда даже множественных узлов. В последнем случае возникает бугристая форма железистого рака.
По мере постепенного увеличения размеров опухоли кожа над ней несколько приподнимается, а в дальнейшем начинает отчетливо выбухать. Но при этом сама кожа не изменяется, не срастается с опухолью и не про-растается ею, а по-прежнему остается интактной и подвижной над опухолью. Это объясняется тем, что опухоль, возникшая внутри тарзальной пластинки, обладает только экспансивным ростом, не инфильтрирует и не прорастает прилегающие ткани, а только раздвигает их.
Первоначально она остается отграниченной в толще пластинки и едва касается как кожи, так и подлежащей круговой мышцы. По мере дальнейшего роста она вырастает над пластинкой и начинает отодвигать кожу. Опухоль достигает более или менее заметных размеров обычно не ранее чем через год. Однако и в этот период рост опухоли остается экспансивным и идет путем одновременного раздвигания кожи и конъюнктивы, вызывая на последней лишь перифокальные воспалительные явления.
Истинная железистая опухоль века, вследствие своего развития из мейбомиевой железы и локализации в толще тарзальной пластинки клинически очень напоминает халязион, представляющий собой хроническое воспаление мейбомиевой железы, чаще всего принимается за таковой и под этим видом удаляется. Это тем более естественно, что клиническая дифференциация затруднена и что часто наблюдаемый халязион представляет собой обыденное явление в офтальмологической клинике, а аденогенный рак, наоборот,— исключительная редкость.
При расположении железистой опухоли ближе к конъюнктивальной поверхности она в начальной стадии развития вызывает только гиперемию конъюнктивы, потом приводит к воспалению последней, а затем уже начинает выпячивать се. По мере роста и последующего увеличения опухоли, она все больше и больше приподнимает и натягивает конъюнктиву и тем: самым больше контактирует с ней, усиливая сперва воспалительный процесс, а затем вызывая и воспалительный отек всей соединительной оболочки века (хемоз). Нередко такой хемоз приводит к возникновению слипчивого конъюнктивита, а последний в свою очередь — к симблефарону, что является характерным для аденогенного рака.
Позже, по мере увеличения и усиления роста опухоли на передней поверхности века начинают выступать безболезненные одиночные или множественные узелковые образования хрящевой плотности, размером от лесного до грецкого ореха или все веко принимает ясно выраженную дольчатость. Начинают появляться первые функциональные расстройства века — ограничение подвижности его, в особенности верхнего.

Если в этот период вывернуть веко, то перед нами предстанет папиллярно разбухшая конъюнктива, сквозь которую заметна просвечивающая бледно-желтая, иногда бугристая опухоль мейбомиевой железы. Сама же конъюнктива не изъязвлена, но может быть покрыта мелкими серыми узелками.
Увеличение роста опухоли приводит к дальнейшему ограничению подвижности века, к появлению птоза. В дальнейшем веко начинает оттесняться от глазного яблока увеличивающейся плотной опухолью. Однако и при таком закрытом веке опухоль все же длительно не прорастает кожу и она продолжает оставаться достаточно подвижной либо (при значительном натяжении) ограниченно подвижной. Потом кожа истончается и атрофируется и уже значительно позже спаивается с опухолью. После спаяния с кожей века опухоль может и прорасти ее, но опять-таки не по всей поверхности сильно увеличенного века, а только в некоторой части его.
В этой стадии опухолевого роста аденогенный рак обычно скорее прорастает конъюнктиву, чем кожу века. Конъюнктива века в каком-либо месте прорывается и через образовавшееся отверстие выступает серовато-красного цвета опухоль вида цветной капусты. На перфорации возникает раковая язва с плотным, неровным, легко кровоточащим дном и индурированными краями. Опухолевая язва начинает распространяться по конъюнктиве, переходит на конъюнктиву склеры, прорастает се, распространяется на слезное мясцо, начинает врастать в глазное яблоко и, наконец, проникает даже в орбиту. Такие случаи всегда оканчиваются летально.
При локализации аденогенного рака на нижнем веке опухолевая язва, распространяясь по конъюнктиве до свободного края века, переходит через межреберное пространство и начинает распространяться по коже века, вызывая значительно более раннее изъязвление кожи, чем в случае поражения верхнего века. Следуя распространению опухоли, изъязвление века начинается со стороны свободного края его, с переднего ребра, распространяется вдоль последнего и оттуда спускается книзу, к основанию века.
Весь процесс в общем протекает совершенно безболезненно и только в отдельных случаях сопровождается резкими болями.
Конъюнктивальное распространение аденогенного рака, прорастание его в конъюнктиву века и склеру, распространение на глазное мясцо и прорастание глазного яблока, естественно, способствуют распространению опухоли по орбитальной клетчатке и определяет высокую степень злокачественности рака. Поражение орбитальной клетчатки и глазного яблока или даже одно только срастание последнего с веком уже вызывает необходимость обязательной экзентерации глазницы.
Недифференцированный аденогенный рак желудка
Одной из морфологических характеристик злокачественных новообразований является степень их дифференцировки. Дифференцировка клеток — это реализация заложенной в них генетической программы, благодаря которой происходит их развитие и возможность выполнения профильных функций. При злокачественной трансформации дифференцировка нарушается, появляются признаки атипии, и нарушается структура ткани. У недифференцированных опухолей изменения настолько серьезны, что их невозможно идентифицировать с какой-либо тканью. Такие клетки не могут выполнять никакие функции за исключением питания и размножения.
Недифференцированный аденогенный рак желудка — это злокачественная опухоль, которая обладает выраженными признаками атипии, отличается злокачественным течением, склонностью к быстрому метастазированию и местному распространению.
Недифференцированный рак желудка — это злокачественная опухоль, которая обладает выраженными признаками тканевого атипизма, отличается крайне высоким злокачественным течением, склонностью к быстрому метастазированию и местному распространению.
Причины возникновения и группы риска
Причины развития аденогенного рака желудка до конца непонятны. Достоверно известно только то, что здоровая клетка перерождается в злокачественную под влиянием онкогенных процессов или мутаций. К их возникновению могут привести следующие факторы:
- Хронический гастрит атрофического типа. При этом важна локализация и степень его распространения. Если очаги гастрита локализуются в теле желудка, риски повышаются в 3-5 раз, при поражении антрального отдела — в 18, а при тотальном поражении риски увеличиваются в 90 раз.
- Особенности диеты — употребление большого количества острых блюд, копченостей, маринадов, алкоголя.
- Хеликобактерный гастрит.
- Курение.
- Наличие в анамнезе хирургических вмешательств на желудке.
- Наследственная предрасположенность.
- Работа с канцерогенными веществами — асбест, химическое производство и др.
В группу риска входят люди, имеющие заболевания желудка, например гастриты, полипы, язвы. Чтобы вовремя заметить развитие рака, им рекомендуется проходить регулярное обследование у гастроэнтеролога.
Классификация
В зависимости от степени распространения недифференцированного рака желудка выделяют несколько стадий заболевания:
- 0 стадия — рак не выходит за пределы эпителиального слоя желудочной стенки.
- 1 стадия — рак прорастает мышечный слой стенки желудка.
- 2 стадия — рак распространяется на более глубокие слои желудочной стенки. Могут быть метастазы в регионарные лимфатические узлы.
- 3 стадия — поражается самый поверхностный слой желудочной стенки — серозная оболочка. Опухоль выходит за пределы органа и поражает близлежащие органы и лимфатические узлы.
- 4 стадия — имеются отдаленные метастазы.
Недифференцированные формы рака прогрессируют очень быстро, поэтому их обычно обнаруживают на распространенных стадиях.

Симптомы рака желудка
Злокачественные опухоли желудка, в том числе и недифференцированный рак на начальных стадиях, никак себя не проявляют. Либо его симптомы сходны с другими заболеваниями, и пациенты не считают нужным обращаться к врачу, решают проблему самостоятельно. При этом могут наблюдаться:
- Нарушение аппетита, вплоть до отвращения к отдельным видам пищи, например к мясу.
- Диспепсия — вздутие и урчание в животе, тошнота, отрыжка и др.
- Потеря веса, слабость и апатия.
На распространенных стадиях наблюдается более четкая картина:
- Боль. Она носит постоянный, давящий характер, может усиливаться после приема пищи, иррадиировать в поясницу или область сердца.
- При больших размерах новообразования, инфильтративном росте и распространении на стенку пищевода может развиваться дисфагия — нарушение прохождения пищевого комка. При этом у пациента может отмечаться рвота фонтаном, электролитные и гиповолемические нарушения.
- При распаде опухоли возможно развитие кровотечения. При этом может быть рвота желудочным содержимым цвета кофейной гущи, или дегтеобразный стул (мелена).
Диагностика недифференцированного рака
В рамках диагностики проводится комплекс мероприятий:
- Эндоскопия желудка и пищевода. Это исследование позволяет не только обнаружить опухоль, но и взять биопсию.
- Эндоскопическое УЗИ. Позволяет определить степень инвазии рака в стенку желудка и вовлечение в процесс рядом расположенных органов и анатомических структур.
- Абдоминальное УЗИ. Проводится для поиска метастазов в лимфоузлы и органы брюшной полости.
- Рентгеноконтрастное исследование. Позволяет обнаружить опухоли с подслизистым типом роста, которые сложно увидеть во время ФГДС, определить распространённость рака, оценить степень стеноза органа.
- КТ — проводится для поиска отдаленных метастазов.
- Диагностическая лапароскопия. Позволяет обнаружить распространение опухоли на серозные оболочки, а также диагностировать интраперитонеальную диссеминацию.
- Определение онкомаркеров — РЭА, СА 19-9, СА 72-4. Эти исследования необходимы для отслеживания динамики процесса и определения рецидива или прогрессирования заболевания.
Лечение недифференцированного рака
Лечение недифференцированного рака желудка проводится по протоколам, аналогичным аденокарциноме. В основном применяется комбинированное лечение, включающее операцию и химиотерапию. При нерезектабельных опухолях проводится только химиотерапия, а хирургическое вмешательство выполняется только при развитии жизнеугрожающих состояний.

При лечении недифференцированных форм рака желудка применяют комбинированное лечение, включающее химиотерапию и операцию. При нерезектабельных опухолях используется химиотерапия.
В рамках оперативного лечения рака желудка применяют полное удаление органа или резекцию его части. Объем вмешательства определяется локализацией новообразования и местной распространенностью процесса. При необходимости проводят резекцию скомпрометированных органов, например, пищевода.
Кроме того, производится удаление регионарных лимфатических узлов 1 и 2 порядка. При локализации рака в кардиальном отделе рассматривается вопрос удаления лимфоузлов средостения.
Химиотерапия может выполняться в периоперационном или адъювантном режиме.
Периоперационная
химиотерапия
Адъювантная
химиотерапия
Она начинается через 4-6 недель после операции, если нет противопоказаний, и проводится в течение 6 месяцев. Применяют схемы XELOX или CAPOX.
Признаками нерезектабельности рака желудка являются наличие отдаленных метастазов и диссеминированные формы заболевания (канцероматоз). В этом случае в качестве лечения применяют химиотерапию первой линии на протяжении полугода, после этого лечение прекращают и устанавливают наблюдение за пациентом до прогрессирования заболевания. Если прогрессирование наступило не ранее чем через полгода от окончания последнего курса химиотерапии, возможно применение схемы первой линии. В противном случае назначается лечение второй и последующих линий.
Восстановление после лечения
Поскольку оперативное лечение рака желудка предполагает полное или частичное удаление органа, пациента ожидают серьезные ограничения в плане питания, так как основная нагрузка ложится на тонкий кишечник. Поэтому пациенту предписывается щадящая диета, исключающая употребление грубой, жирной и трудноперевариваемой пищи.
Особое внимание уделяется режиму дня. Пациенту рекомендуется много отдыхать, ограничить свою нагрузку в плане повседневных дел. В то же время желательно поддерживать общение с близкими людьми, поскольку это благоприятно сказывается на психоэмоциональном состоянии.
Метастазирование
Недифференцированный рак желудка может метастазировать лимфогенным, гематогенным и имплантационным путем. При лимфогенном метастазировании первоначально поражаются регионарные лимфоузлы, локализующиеся в брюшной полости, забрюшинном пространстве и паракардиальной области. Затем поражаются более отдаленные коллекторы — надключичные лимфоузлы, подмышечные, параректальные. При гематогенном метастазировании поражаются печень, легкие, почки и другие органы. Имплантационное метастазирование реализуется посредством контакта опухолевых клеток с воспринимающей поверхностью. В данном случае это брюшина, диафрагма, перикард и плевра.
Осложнения
- Кровотечения из опухоли. Они проявляются рвотой «кофейной гущей» и дегтеобразным стулом (меленой). В этом случае проводится неотложное эндоскопическое исследование и попытка остановки кровотечения. При неудаче проводится лапаротомия.
- Опухолевый стеноз. Это осложнение приводит к невозможности продвижения пищи по пищеварительному тракту и развитию алиментарных нарушений. Чтобы устранить стеноз применяют реканализацию, баллонную дилятацию, стентирование. В тяжелых случаях накладывают обходные анастомозы или выводят гастростому.
- Асцит — скопление жидкости в брюшной полости. Для борьбы с асцитом применяется внутриполостная химиотерапия. При больших объемах жидкости проводится лапароцентез — эвакуация содержимого посредством пункции.
Прогноз и профилактика
Прогноз зависит от стадии, но чаще он неблагоприятный. Пятилетняя выживаемость колеблется в пределах 15-18%. Учитывая то, что опухоль чаще всего развивается на фоне имеющихся проблем с желудком, для предотвращения ее развития и своевременной диагностики предраковых состояний рекомендуется регулярно проходить обследование у гастроэнтеролога.
Наличие в штате «Евроонко» высококвалифицированных врачей-онкологов и смежных специалистов позволяет подбирать оптимальное лечение. Применение самых современных протоколов лечения позволяет достигать удовлетворительных результатов даже в самых сложных случаях.
Читайте также:
- Воздействие извести, кальция карбида, соды, никели, скипидара на кожу
- От чего зависит наследственность? Первичные половые клетки
- Клиника и диагностика иммунонегативного гломерулонефрита при васкулитах
- Гиперпаратиреоз. Клиника и диагностика
- Возможности магнитно-резонансной томографии (МРТ) в нейрохирургии
